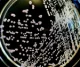
BẠN CÓ BIẾT SACHAROMYCES CEREVISIAE LÀ GÌ? NẤM MEN CÓ LỢI HAY CÓ HẠI TRONG CHĂN NUÔI ?

Những “anh hùng tí hon” xử lý môi trường
1. Nhóm Bacillus spp. (sản phẩm có chứa B. megaterium, B. licheniformis)
- Bacillus spp. là nhóm vi sinh vật tiết enzyme như amylase, protease, cellulase, xylanase... giúp phân hủy nhanh các hợp chất hữu cơ, gây ức chế nhiều nhóm sinh vật, tham gia vào quá trình amoni hóa…có tác dụng lớn vào việc xử lý môi trường
- Cơ chế hoạt động của Bacillus
+ Bacillus giúp phân hủy nhanh các hợp chất hữu cơ, lipid, cellulose cải thiện độ tơi xốp
+ Bacillus tham gia vào quá trình amoni hóa, phản nitrit và nitrat khử mùi và các khí độc hại
+ Bacillus tiết kháng sinh ức chế nhiều nhóm vi sinh vật gây thối, gây hại
+ Bacillus làm giảm lượng khí H2S và độc tố sinh ra

2. Nhóm Lactobacillus (sản phẩm có chứa Lactobacillus acidophilus)
- Ở ngoài môi trường không khí bình thường, lợi khuẩn lactobacillus có khả năng phân nhỏ đường và các protein trong hợp chất hữu cơ sau đó chuyển hóa thành axit lactic sau quá trình ủ men, tạo nên một môi trường axit làm hạn chế sự phát triển của vi khuẩn có hại.